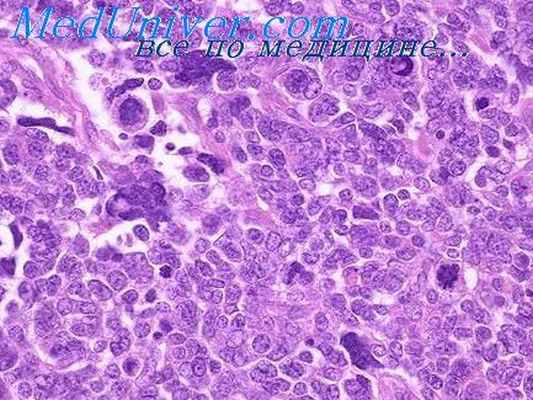
опухоль вильмса

Распространенность опухоли Вильмса. Морфология опухоли Вильмса
Добавил пользователь Дмитрий К. Обновлено: 07.01.2026
Опухоль Вильмса (нефробластома) встречается преимущественно у детей 3-5 лет. Частота возникновения данного заболевания снижается по мере взросления ребенка. У взрослых опухоль Вильмса встречается очень редко. В Соединенных Штатах диагностируется приблизительно 500-600 новых случаев нефробластомы ежегодно. Опухоль Вильмса составляет около 6% всех случаев детской онкологии.
Что такое опухоль Вильмса?
Как правило, опухоль Вильмса достигает довольно крупных размеров, перед тем как ее удается обнаружить. Тем не менее, обычно заболевание диагностируется до начала метастазирования. Болезнь может распространяться и в другие органы, зачастую наблюдается поражение легких и брюшных лимфатических узлов.
Каковы факторы риска развития опухоли Вильмса?
В большинстве случаев причина развития нефробластомы остается неизвестной.
Тем не менее, известно несколько факторов риска развития данного заболевания:
- Возраст: средний возраст пациентов с опухолью Вильмса составляет около 3-4 лет.
- Расовая / этническая принадлежность: у детей афроамериканцев риск развития нефробластомы слегка выше, чем у детей европеоидной расы. Самый низкий уровень заболеваемости – среди детей американцев азиатского происхождения.
- Пол: девочки подвержены несколько более высокому риску появления болезни, чем мальчики.
- Семейный анамнез: в анамнезе примерно 1-2% детей с опухолью Вильмса упомянут один или нескольких родственников с данной болезнью.
- Врожденные дефекты: некоторые врожденные дефекты (такие как аниридия, гемигипертрофия, крипторхизм и гипоспадия), которые не связаны с каким-либо генетическим синдромом, также повышают риск развития нефробластомы у детей.
- Генетические синдромы: прослеживается тесная связь между возникновением нефробластомы и наличием некоторых видов наследственных синдромов (некоторые их них крайне редки). Синдромы, связанные с возникновением опухоли Вильмса:
- Синдром WAGR;
- Синдром Дениса-Драша и синдром Фрейзера;
- Синдром Беквита-Видеманна;
- Дополнительные синдромы, менее тесно связанные с опухолью Вильмса: синдром Перлмана, синдром Сотоса, синдром Симпсона-Голаби-Бемеля, синдром Блума, синдром Ли-Фраумени и синдром трисомии 18 хромосомы
Каковы симптомы опухоли Вильмса?
Нефробластома может достичь довольно крупных размеров, прежде чем появятся какие-либо симптомы. В данный период ребенок может выглядеть здоровым, не выказывая никаких изменений в поведении.
Наиболее распространенные симптомы опухоли Вильмса:
- Припухлость или крупная шишка в области живота (может быть болезненной);
- Повышение температуры тела;
- Тошнота;
- Потеря аппетита;
- Одышка;
- Запоры;
- Кровь в моче;
- Повышенное артериальное давление.
Какие типы опухоли Вильмса бывают??
Существуют два основных типа нефробластомы, классифицируемых преимущественно по гистологическим характеристикам (внешний вид под микроскопом).
- Благоприятный вариант нефробластомы: раковые клетки имеют аномальный внешний вид, но их ядра не являются слишком крупными или искаженными. Этот вариант опухоли Вильмса встречается гораздо чаще, и при своевременном лечении можно достичь благоприятного исхода.
- Анапластический вариант нефробластомы: внешний вид раковых клеток очень разнообразный. Обычно ядра данных клеток довольно крупные и искаженные (признаки анаплазии). При диффузном варианте признаки анаплазии наблюдаются по всей опухоли. Очаговая анаплазия характеризуется наличием ограниченных очагов искаженных клеток.
Кроме этих двух гистологических типов нефробластомы, крайне важно определить стадию заболевания (степень распространения).
В соответствии с инструкциями Детской онкологической группы существует пять стадий нефробластомы:
- Стадия I: около 20% всех случаев; опухоль ограничена почкой, существует возможность полного хирургического удаления.
- Стадия II: около 22% всех случаев; опухоль распространяется за пределы почки, однако существует возможность полного хирургического удаления.
- Стадия III: около 32% всех случаев; опухоль ограничена брюшной полостью, полное хирургическое удаление невозможно.
- Стадия IV: около 20% всех случаев; болезнь проникла в кровоток и может поражать другие органы (чаще всего печень или легкие).
- Стадия V: около 6% всех случаев; в процессе диагностики выявляется поражение обеих почек (двусторонний вариант).
Что такое опухоль Вильмса?
Как правило, опухоль Вильмса достигает довольно крупных размеров, перед тем как ее удается обнаружить. Тем не менее, обычно заболевание диагностируется до начала метастазирования. Болезнь может распространяться и в другие органы, зачастую наблюдается поражение легких и брюшных лимфатических узлов.
Каковы факторы риска развития опухоли Вильмса?
В большинстве случаев причина развития нефробластомы остается неизвестной. Тем не менее, известно несколько факторов риска развития данного заболевания:
- Возраст: средний возраст пациентов с опухолью Вильмса составляет около 3-4 лет.
- Расовая / этническая принадлежность: у детей афроамериканцев риск развития нефробластомы слегка выше, чем у детей европеоидной расы. Самый низкий уровень заболеваемости – среди детей американцев азиатского происхождения.
- Пол: девочки подвержены несколько более высокому риску появления болезни, чем мальчики.
- Семейный анамнез: в анамнезе примерно 1-2% детей с опухолью Вильмса упомянут один или нескольких родственников с данной болезнью.
- Врожденные дефекты: некоторые врожденные дефекты (такие как аниридия, гемигипертрофия, крипторхизм и гипоспадия), которые не связаны с каким-либо генетическим синдромом, также повышают риск развития нефробластомы у детей.
- Генетические синдромы: прослеживается тесная связь между возникновением нефробластомы и наличием некоторых видов наследственных синдромов (некоторые их них крайне редки). Синдромы, связанные с возникновением опухоли Вильмса:
- Синдром WAGR;
- Синдром Дениса-Драша и синдром Фрейзера;
- Синдром Беквита-Видеманна;
- Дополнительные синдромы, менее тесно связанные с опухолью Вильмса: синдром Перлмана, синдром Сотоса, синдром Симпсона-Голаби-Бемеля, синдром Блума, синдром Ли-Фраумени и синдром трисомии 18 хромосомы.
Каковы симптомы опухоли Вильмса?
Нефробластома может достичь довольно крупных размеров, прежде чем появятся какие-либо симптомы. В данный период ребенок может выглядеть здоровым, не выказывая никаких изменений в поведении. Наиболее распространенные симптомы опухоли Вильмса:
- Припухлость или крупная шишка в области живота (может быть болезненной);
- Повышение температуры тела;
- Тошнота;
- Потеря аппетита;
- Одышка;
- Запоры;
- Кровь в моче;
- Повышенное артериальное давление.
Какие типы опухоли Вильмса бывают?
Существуют два основных типа нефробластомы, классифицируемых преимущественно по гистологическим характеристикам (внешний вид под микроскопом).
- Благоприятный вариант нефробластомы: раковые клетки имеют аномальный внешний вид, но их ядра не являются слишком крупными или искаженными. Этот вариант опухоли Вильмса встречается гораздо чаще, и при своевременном лечении можно достичь благоприятного исхода.
- Анапластический вариант нефробластомы: внешний вид раковых клеток очень разнообразный. Обычно ядра данных клеток довольно крупные и искаженные (признаки анаплазии). При диффузном варианте признаки анаплазии наблюдаются по всей опухоли. Очаговая анаплазия характеризуется наличием ограниченных очагов искаженных клеток.
Кроме этих двух гистологических типов нефробластомы, крайне важно определить стадию заболевания (степень распространения). В соответствии с инструкциями Детской онкологической группы существует пять стадий нефробластомы:
Распространенность опухоли Вильмса. Морфология опухоли Вильмса
Распространенность опухоли Вильмса. Морфология опухоли Вильмса
Опухоль Вильмса встречается исключительно в детском возрасте, преимущественно в первые годы жизни, с пиком в 5 лет, половая разница небольшая (1,25: 1) с преимуществом мальчиков. Согласно данным Н. Marsden и J. Steward (1976), на 82 случая в 41 опухоль возникла в левой почке, в 38 в правой и всего в 3 случаях была двусторонней. По данным P. Campbell (1976), двусторонние опухоли встречаются в 4% случаев. Описывается в редких случаях эктопическое расположение опухоли в средостении, около нормальной почки, рядом с перешейком подковообразной почки и в паховом канале с метастазами в семенной канатик.
Опухоль имеет беловатую тонкую соединительнотканную капсулу и долго растет экспансивно, сдавливая почку. Последняя распластана на ее поверхности и атрофична. Капсула легко повреждается, и тогда опухоль дает инвазивный рост. Поверхность опухоли бугристая, на разрезе беловатая с очагами некроза и кровоизлияний, с вторичными кистами. Размеры бывают чрезвычайно большими, достигающими 20 см в диаметре и массой в 1500 г.
Опухоль состоит из солидных полей и тяжей клеток с овальным и круглым ядром, в центре которых формируются трубочки, напоминающие почечные канальцы, реже встречаются образования, сходные с почечными клубочками. Между полями эпителиальных клеток располагается рыхлая незрелая соединительная ткань с большим или меньшим количеством вытянутых клеток. В этой межуточной ткани могут встречаться группы поперечнополосатых мышечных волокон, сосуды разного калибра, гладкие мышцы, жировая ткань, реже хрящ и костные балки, еще реже производные нейроэктодермы. Зависимость клинического течения опухоли от степени дифференцировки ее почечных структур послужила поводом для создания классификации гистологических типов опухоли.
![опухоль вильмса]()
Так, В. Jereb и В. Sandstedt (1973) выделили три типа опухоли: 1) с высокой дифференцировкой тубулярпых и гломерулярных структур; 2) с наличием дифференцировки только тубулярных структур и 3) малодифференцироваиный. Соответственно этому наблюдалась при первом типе выживаемость в 75%, при втором —в 25%, при третьем — в 19%.
В. Н. Сухова выделяет также три основных гистологических типа: 1) недифференцированный (42 наблюдения автора); 2) с начальной многопрофильной дифференцировкой (46 наблюдений) и 3) дифференцированный (60 наблюдений), в котором в свою очередь выделяются варианты: а) нефрогенный; б) мезенхимальный, в) миогенный, типа рабдомиобластомы и г) нейрогенный.
Н. Marsden и J, Steward (1976) выделяют особую кистозную форму опухоли, в которой имеется сочетание дифференцированной нефробластомы тубулярного типа с образованием истинных кист различных размеров, выстланных уплощенными клетками. Эта поликистозная нефробластома отличается более благоприятным прогнозом по сравнению с типичной опухолью Вильмса. Опухоль Вильмса часто прорастает почечную вену, иногда и нижнюю полую вену. Дает метастазы в лимфатические узлы, легкие, печень, другую почку, редко в кости. Прогноз зависит от гистологического типа опухоли. После операции возрастает частота метастазирования.
Информация на сайте подлежит консультации лечащим врачом и не заменяет очной консультации с ним.
См. подробнее в пользовательском соглашении.Опухоль Вильмса
Опухоль Вильмса – эмбриональный рак почки, состоящий из таких гистологических элементов, как бластема, строма и эпителий. Генетические аномалии вовлечены в патогенез, но семейное наследование связано только с 1–2% случаев. Диагноз ставят на основании УЗИ, КТ органов брюшной полости или МРТ. Лечение может включать хирургическую резекцию, химиотерапию и лучевую терапию.
В некоторых случаях были выявлены хромосомные делеции WT1, гена-супрессора опухоли Вильмса. Другие связанные с ними генетические отклонения включают делеции WT2 (второй ген-супрессор опухоли Вильмса), утрату гетерозиготности 16q и 1p и инактивацию гена WTX.
Около 10% случаев проявляются с другими врожденными аномалиями, особенно мочеполовыми, но также распространена и гемигипертрофия (асимметрия тела). WAGR синдром представляет собой сочетание опухоли Вильмса (с делецией WT1,), аниридии, пороков развития мочеполовой системы (например, гипоплазии, поликистоза, гипоспадии, крипторхизма) и умственной отсталости.
Симптомы и признаки опухоли Вильмса
Наиболее частый симптом – безболезненное пальпируемое новообразование в брюшной полости. Менее частые признаки включают боль в животе, гематурию, лихорадку, анорексию, тошноту и рвоту. Гематурия может быть микроскопической или макроскопической. Может возникнуть гипертензия и она может иметь переменную степень тяжести.
Диагностика опухоли Вильмса
УЗИ брюшной полости, КТ или МРТ
УЗИ органов брюшной полости позволяет определить, является ли образование кистозным или солидным и вовлечена ли почечная или полая вены. КТ или МРТ органов брюшной полости необходимы для определения распространенности опухоли и выявления распространения в регионарные лимфатические узлы, контралатеральную почку или печень. КТ органов грудной клетки рекомендуется для выявления метастатического поражения легких при первоначальной диагностике.
Диагноз опухоли Вильмса, как правило, предполагается на основе результатов методов визуализации, так что на момент постановки диагноза у большинства пациентов проводится нефрэктомия, а не биопсия. Биопсия не проводится из-за риска заражения брюшины опухолевыми клетками, которые будут распространять рак и таким образом изменят стадию с более низкой на более высокую, требующую более интенсивной терапии.
Во время операции берется образец регионарных лимфатических узлов для патологического и хирургического стадирования (см. также Стадирование Опухоли Вильмса Национального института рака [NCI Stages of Wilms Tumor]).
Прогноз опухоли Вильмса
Прогноз опухоли Вильмса зависит от
От гистологического варианта (благоприятная или неблагоприятная)
Стадии на момент постановки диагноза
Возраст пациентов (пожилой возраст ассоциируется с плохим прогнозом)
Исход для детей с опухолью Вильмса благоприятный. Частота излечения на начальных стадиях заболевания (локализованы в почке) варьируется в пределах 85–95%. Даже дети с распространенными стадиями имеют благоприятный прогноз; частота излечения варьируется от 60% (неблагоприятная гистология) до 90% (благоприятная гистология).
Опухоль может рецидивировать, обычно в течение 2 лет после постановки диагноза. Лечение у детей с рецидивирующим раком возможно. Исход после рецидива лучше у детей, изначально имевших более низкую стадию заболевания, у которых опухоль рецидивировала в месте, которое не было облучено, у кого прошло > 1 года после проявления и которые получали менее интенсивное лечение на начальном этапе.
Лечение опухоли Вильмса
Хирургическое удаление и химиотерапия
Лучевая терапия для пациентов с более высокой стадией/риском болезни
Первоначальное лечение односторонней опухоли Вильмса - это первичная хирургическая резекция с последующей адъювантной химиотерапией. Для излечения определенной группы молодых пациентов с небольшими опухолями достаточно применения только хирургического метода. Тип химиотерапевтического препарата и продолжительность терапии зависят от результатов гистологического исследования и стадии опухоли. Режим химиотерапии зависит от группы риска, но, как правило, состоит из актиномицина D (дактиномицина) и винкристина с доксорубицином, или без него. Для более агрессивных опухолей используются интенсивные многокомпонентные режимы химиотерапии.
Дети с очень большими неоперабельными опухолями или двусторонними опухолями являются кандидатами на химиотерапию с последующим повторным обследованием и отсроченной резекцией.
Детям, с болезнью более высокой стадии или опухолями, которые поражают региональные лимфатические узлы, проводят лучевую терапию.
Дополнительная информация
Ниже следует англоязычный ресурс, который может быть информативным. Обратите внимание, что The manual не несет ответственности за содержание этого ресурса.
National Cancer Institute: Stages of Wilms Tumor
Авторское право © 2022 Merck & Co., Inc., Rahway, NJ, США и ее аффилированные лица. Все права сохранены.
Лечение опухоли Вильмса в Германии
Опухоль Вильмса (нефробластома) – злокачественное новообразование почки, возникающее у детей. Названное по имени врача, который впервые описал заболевание в 1899 году. Это эмбриональная опухоль, которая растет из развивающихся тканей почек. Болезнь в 75% случаев диагностируется до 5-летнего возраста и может быть врожденной. Остальные 25% пациентов – это дети от 6 до 14 лет. У взрослых опухоль Вильмса почти не встречается.
На портале Booking Health представлены 67 немецких клиник по лечению опухоли Вильмса
Диагностика опухоли Вильмса
Для установления диагноза применяются методы визуализации:
- УЗИ
- Компьютерная томография
- МРТ
Эти методы позволяют не только обнаружить опухоль Вильмса в почке, но также оценить её величину, распространенность онкопроцесса, выявить метастазы, в том числе отдаленные: в печени, легких, костях.
Другие диагностические исследования:
- Определение уровня катехоламинов в моче. Применяется после обнаружения новообразования с помощью методов визуализации. Требуется, если нужно отличить опухоль Вильмса от нейробластомы, которая может развиваться из тканей надпочечника.
- Эксцизионная биопсия. Фрагмент удаленной опухоли отправляется на гистологическое исследование. Строение образца не только позволяет удостовериться в диагнозе, но и определить, из каких клеток состоит нефробластома. От этого зависит прогноз для жизни и лечебная тактика. Эксцизионная биопсия обычно проводится во время хирургической операции. Гистологическое исследование проводят интраоперационно.
Рекомендуемые клиники для диагностики опухоли Вильмса в Германии:
![Университетская клиника Эссена]()
Университетская клиника Эссена
![Детская диагностическая клиника М1 Мюнхен]()
Детская диагностическая клиника М1 Мюнхен
![Высшая медицинская школа Ганновера (MHH)]()
Высшая медицинская школа Ганновера (MHH)
Лечение опухоли Вильмса
Схема лечения определяется стадией патологического процесса и гистологическим типом новообразования.
Стадии опухоли Вильмса:
- 1 стадия – опухоль ограничена почкой или удалена
- 2 стадия – опухоль выходила за пределы почки, но была удалена полностью
- 3 стадия – большой размер опухоли, наличие метастазов в лимфатических узлах, остаточная опухоль в краях раны после удаления, либо во время операции произошел разрыв опухоли
- 4 стадия – есть отдаленные метастазы
- 5 стадия – опухоль Вильмса присутствует в обеих почках
На всех стадиях проводится удаление опухоли Вильмса – это основа лечения. Используется радикальная или частичная нефрэктомия. Чаще почка удаляется полностью.
Кроме неё также удаляется:
- Жировая ткань
- Лимфатические узлы
- Мочеточник
- Надпочечник
При наличии опухолей в обеих почках (около 5% детей) применяется одна из трех тактик лечения:
- Удаляются фрагменты обоих почек, пораженные опухолью (при небольших размерах новообразований)
- Удаляется одна почка полностью (при большом размере опухоли), а вторая – частично
- Обе почки удаляются. Пациент получает диализ несколько раз в неделю. Затем возможна пересадка донорской почки
Химиотерапия дополняет хирургическое лечение на всех стадиях, но на первой применяется не всегда, а лишь в отдельных случаях, если риск рецидива оценивается как высокий. В клиниках Европы препараты назначаются до операции, в Америке – после вмешательства. Влияние этих терапевтических схем на исход заболевания пока что изучается. В настоящее время неизвестно, какой подход к химиотерапии при опухоли Вильмса более эффективен.
Лучевая терапия иногда используется перед операцией, но только если новообразование выходит за пределы почки. Она позволяет облегчить удаление нефробластомы и снизить риск разрыва опухоли во время операции. Облучение всей брюшной полости используется после операции, если разрыв опухоли все-таки произошел.
Инновационное лечение опухоли Вильмса
В то время как благоприятные гистологические формы опухоли Вильмса успешно излечиваются сочетанием операции и препаратов, неблагоприятные формы этого онкологического заболевания по-прежнему плохо поддаются терапии. Перспективным считается использование препаратов топотекан и иринотекан. Продолжаются исследования, направленные на оценку их эффективности.
Также исследуется возможность проведения трансплантации стволовых клеток. По задумке врачей, она позволит пациентам выдержать более интенсивную химиотерапию, направленную на уничтожение гистологически неблагоприятных типов опухоли Вильмса. На данный момент неизвестно, окажется ли оправданным такой терапевтический подход. В клиническую практику методика лечения пока что не введена.
Рекомендуемые клиники для лечения опухоли Вильмса в Германии:
![Университетская клиника Мюнхенского университета им. Людвига-Максимилиана]()
Университетская клиника Мюнхенского университета им. Людвига-Максимилиана
Распространенность опухоли Вильмса. Морфология опухоли Вильмса
16.05.2022 Иван Августинович, врач-онколог-хирург операционного блока РНПЦ детской онкологии, гематологии и иммунологии. 16.05.2022 !-->
Нефробластома (опухоль Вильмса, WT) является наиболее распространенной опухолью почки у детей, которая может проявляться как в виде единичного узла, так и в виде мультифокального одностороннего поражения либо двусторонней опухоли.
В структуре злокачественных опухолей у детей нефробластома занимает четвертое место, следуя за гемобластозами, опухолями ЦНС и саркомами мягких тканей. Нефробластома составляет примерно 7–8 % всех злокачественных опухолей у детей.
Согласно данным Американского онкологического общества, ежегодно в США выявляется 500–600 новых случаев нефробластомы у детей, или 5 % от всех злокачественных опухолей. По данным детского канцер-субрегистра Республики Беларусь, ежегодно регистрируется 8–9 новых случаев нефробластомы на 1 млн детского населения, что также составляет 5 % от всех злокачественных опухолей. У 78 % детей опухоль диагностируется в возрасте 1–5 лет, пик заболеваемости приходится на 3–4-й год. У взрослых нефробластомы встречаются редко.
История вопроса
![Avgustinovich]()
Иван Августинович, врач-онколог-хирург операционного блока РНПЦ детской онкологии, гематологии и иммунологии Первым описал нефробластому немецкий патологоанатом и хирург Макс Вильмс. Едва ли он осознавал, что его диссертация «Смешанные опухоли почки» (1899) свяжет его имя с самой распространенной опухолью почки у детей. В своей работе он исследовал 9 (в основном больших по своим размерам) опухолей у детей в возрасте от 11 недель до 11 лет. Макс Вильмс описал опухоль как образование с округлыми клетками (миосаркома) с содержанием эпителиальных структур, в которых было установлено сходство с эмбриональной почкой. Он подозревал, что компонент, названный им круглоклеточной саркомой, представляет собой опухолевые эмбриональные клетки с потенциалом дифференцировки в мезенхиму и эпителий почки, и предположил его происхождение от «бластемы почки», связав онкогенез этих опухолей с почечной эмбриологией.
В первой половине 20-го века хирургическое лечение было единственным методом терапии, частый летальный исход был отчасти обусловлен большими размерами опухоли. Ранняя попытка (1916) лечения неоперабельной нефробластомы при помощи рентгеновского облучения показала, что рентгеновские лучи могут уменьшить опухоль, и это дало первоначальный успех, но метод не получил широкого распространения. Постепенно методы хирургического лечения улучшались, что позволяло спасти часть детей, в частности с небольшими размерами опухоли. Прорыв произошел при комбинировании хирургического лечения с облучением и химиотерапией, о чем в 1956 году сообщила Сидни Фарбер с коллегами, в результате чего 2-летняя выживаемость составила 81 %. Следующим шагом стало создание двух основных исследовательских групп — NWTS и SIOP, которые оказали огромное влияние на успех лечения нефробластомы.
Национальная группа по исследованию опухоли Вильмса (NWTS, National Wilms Tumor Study Group, США), основанная в 1969 году, собрала большое количество пациентов и провела несколько клинических рандомизированных исследований, направленных на оптимизацию лечения для различных групп риска нефробластомы и определения возможных генетических факторов риска. Классификация нефробластомы культового патологоанатома Брюса Беквита, который твердо связал гистопатологию с прогнозами лечения и выявил опухоли с благоприятной или неблагоприятной морфологией, по-прежнему действительна для опухолей без предоперационного лечения.
В Европе небольшая группа преданных своему делу французских врачей в 1961 году открыла клуб детских онкологов, который в 1969 году был преобразован в SIOP — международное общество детских онкологов, членами которого сегодня являются медицинские специалисты из более чем 100 стран мира. SIOP сотрудничает с Группой изучения детского рака Соединенного Королевства (UKCCSG) и немецким Обществом детской онкологии и гематологии (GPOH).
Белорусские детские онкогематологи для лечения нефробластомы в прошлом использовали клинические протоколы как SIOP, так и NWTS. В настоящий момент для лечения детей применяется последний передовой протокол ренальной исследовательской группы SIOP — SIOP RTSG Umbrella, который объединил в себе протокольное лечение наиболее часто встречающихся злокачественных опухолей почек у детей.
Этиология и патогенез
Обычно нефробластома возникает спорадически, в 2 % случаев имеет семейный характер. В норме участки метанефрогенной бластемы, формирующие секреторный аппарат почки (клубочки, извитые канальцы), должны исчезать после 36-й недели беременности, однако у 1 % детей при рождении часть бластемы остается функционирующей. Эти фокусы бластемы описываются как нефрогенные остатки, которые определяются как участки с повышенным риском развития опухоли Вильмса. Судьба нефрогенных остатков двояка: они могут регрессировать или давать малигнизацию, постепенно трансформируясь в нефробластому.
Нефробластома нередко является одним из симптомов врожденных пороков и генетических синдромов. Врожденные аномалии выявляются в 12–15 % случаев опухоли Вильмса. Наиболее часто диагностируются следующие из них: аниридия, гемигипертрофия, синдром Беквита — Видемана, аномалия мочеполового тракта, WARG-синдром, синдром Дениса — Драша.
В начале 1970-х годов американский генетик Альфред Кнудсон, используя предыдущие разработки на гене Rb, предложил две модели туморогенеза при опухоли Вильмса. В первом случае имеет место развитие спорадической нефробластомы, при которой в нефробласте оба аллеля гена WT (Wilms tumor) повреждаются двумя независимыми соматическими мутациями; происходит полная инактивация данного гена, что приводит к развитию опухоли. Мутация носит гомозиготный характер, обнаруживается только в клетках опухоли и не наследуется. Наследственная форма нефробластомы характеризуется передачей мутированной копии гена WT из поколения в поколение. Каждый нефробласт гетерозиготного носителя мутации уже имеет инактивированный аллель WT. Таким образом, для развития нефробластомы достаточно всего одной соматической мутации, затрагивающей оставшуюся копию гена.
В настоящее время эта модель, оставаясь правильной по сути, представляется излишне упрощенной: в патогенез нефробластомы может быть вовлечено множество других генетических поломок.
Клиническая картина
Наиболее частый признак опухоли Вильмса — определяемая пальпаторно опухоль в брюшной полости. Нефробластома может длительное время протекать бессимптомно. Иногда отмечаются боли в животе. Гематурия может выявляться при микроскопическом исследовании. Гипертензия отмечается приблизительно у 25 % пациентов.
Гистологическое строение и классификация
Опухоли почки характеризуются гистологической гетерогенностью. Около 80 % случаев нефробластомы составляют классический вариант опухоли. Гистологическое стадирование предусматривает выделение 3 степеней злокачественности опухолей почки у детей, связанных с прогнозом заболевания. Стадирование применимо для опухолей, которые получали предоперационную химиотерапию, и опухолей, лечение которых началось с хирургического удаления.
Без предоперационной химиотерапии:
- низкий риск: мезобластическая нефрома, кистозная частично дифференцированная нефробластома;
- средний риск: неанапластические варианты нефробластомы, фокальная анаплазия;
- высокий риск: нефробластома — диффузная анаплазия, светлоклеточная саркома почки, рабдоидная опухоль почки.
С предоперационной химиотерапией:
- низкий риск: мезобластическая нефрома, кистозная частично дифференцированная нефробластома, полностью некротизированная нефробластома;
- средний риск: нефробластомы — эпителиальный, стромальный, смешанный, регрессивный типы, нейробластома — фокальная анаплазия;
- высокий риск: нефробластома — бластемный тип, диффузная анаплазия, светлоклеточная саркома почки, рабдоидная опухоль почки.
Клиническое стадирование
В настоящее время группы SIOP и NWTS используют единую систему стадирования нефробластомы, которая является определяющей для лечения:
- 1-я стадия — опухоль локализуется в пределах почки, возможно полное удаление;
- 2-я стадия — опухоль выходит за пределы почки, возможно полное удаление, в т. ч. прорастание капсулы почки, с распространением в околопочечную клетчатку и/или в ворота почки, поражение регионарных лимфатических узлов (стадия II N+); поражение внепочечных сосудов; поражение мочеточника;
- 3-я стадия — опухоль распространяется за пределы почки, возможно неполное удаление, в т. ч. в случае инцизионной или аспирационной биопсии, пред- или интраоперационный разрыв, метастазы по брюшине, поражение внутрибрюшных лимфоузлов (за исключением регионарных), опухолевый выпот в брюшную полость, нерадикальное удаление;
- 4-я стадия — наличие отдаленных метастазов;
- 5-я стадия — двусторонняя нефробластома; варианты двусторонних нефробластом включают: А — поражение одного из полюсов обеих почек; Б — поражение одной почки с вовлечением ворот в опухолевый процесс (тотальное или субтотальное) и одного из полюсов второй почки; С — поражение обеих почек с вовлечением в процесс ворот (тотальное или субтотальное).
Диагностика
Как и при других злокачественных опухолях, диагностика нефробластомы основана на морфологическом заключении. Однако в отношении нефробластомы допускается исключение из традиционного правила «проведение биопсии перед началом химиолучевой терапии».
Во время биопсии возникает нарушение целостности псевдокапсулы, и заключенный в псевдокапсулу опухолевый детрит, имеющий кашицеобразный характер, рассеивается по брюшной полости или по ходу иглы, что увеличивает распространенность опухоли, изменяет клиническую стадию заболевания (автоматически переводит в 3-ю стадию) и ухудшает прогноз. Поэтому у пациентов старше 6 месяцев и младше 16 лет диагноз нефробластомы устанавливают при консервативном обследовании.
Диагностика первичной опухоли основана на выявлении типичных признаков нефробластомы и исключении других заболеваний. В круг дифференциальных диагнозов входят пороки развития почки, гидронефроз, нейрогенные опухоли и другие опухоли забрюшинного пространства, опухоли печени, гамартома. Диагностика нефробластомы и определение стадии включает лабораторные и инструментальные исследования, такие как общеклинические анализы: общий анализ крови и мочи, биохимическое исследование крови, коагулограмма, онкомаркеры, исследование катехоламинов в моче.
Инструментальные методы обследования
- УЗИ органов брюшной полости и забрюшинного пространства — выявление опухоли в трех измерениях и определение объема опухоли. При УЗИ может быть визуализирован опухолевый тромб в нижней полой вене.
- Компьютерная томография органов брюшной полости и забрюшинного пространства с оральным и внутривенным контрастированием (см. рис. 1).
- Магнитно-резонансная томография брюшной полости и забрюшинного пространства без и с контрастным усилением (дает дополнительную информацию о распространенности и связи опухоли с окружающими органами).
- Ангиография выполняется при сомнениях в диагнозе. На ангиограммах обнаруживается патологическая сеть сосудов, выявляется источник кровоснабжения. Ангиографически возможно визуализировать опухолевый тромб в нижней полой вене.
- Радиоизотопное исследование почек — реносцинтиграфия, которая позволяет оценить как суммарную функцию почек, так и отдельно функцию каждой из них.
- Диагностика метастазов включает рентгенографию грудной клетки; при подозрении на метастазы в легкие — КТ органов грудной клетки. УЗИ брюшной полости и забрюшинного пространства также оценивает метастазы в регионарные лимфоузлы, печень, другие органы и ткани, выпот в брюшную полость.
![KT 1]()
Рисунок 1. КТ брюшной полости ребенка с большой нефробластомой с метастазами в печень.
Лечение
Стандартным является комплексное лечение: химиотерапия, хирургическое лечение и лучевая терапия.
Химиотерапия: согласно протоколу SIOP, в течение 4 недель пациент получает предоперационную химиотерапию препаратами винкристин, дактиномицин для 2–3-й стадии; для 4-й стадии препаратами винкристин, дактиномицин, доксорубицин в течение 6 недель. Пациенты с 5-й стадией стадируются локально для каждой почки, и в зависимости от локальной стадии определяется режим предоперационной терапии.
Целью предоперационной химиотерапии является уменьшение размеров опухоли, что снижает риск интраоперационного разрыва псевдокапсулы, регресса метастазов. На 5-й неделе лечения при 2–3-й стадии и на 7-й неделе при 4-й стадии проводится предоперационное обследование, включающее общеклинические и инструментальные исследования, оценку ответа опухоли на химиотерапию.
Затем выполняется хирургическое лечение — радикальное удаление опухоли в объеме туморнефроуретерэктомии либо же резекции почки, биопсия регионарных лимфоузлов, метастазэктомия.
После операции и получения морфологического заключения проводится послеоперационное рестадирование, и в зависимости от гистологического варианта опухоли, поражения лимфоузлов, наличия метастазов либо же их тотального регресса/некроза определяется тактика послеоперационного лечения, которое может включать различные комбинации химиотерапевтических препаратов и добавление лучевой терапии в течение 26–34 недель.
Прогноз нефробластомы при выполнении программной терапии является хорошим. Выживаемость зависит от стадии заболевания и гистологического варианта. Независимо от прогностических факторов 90 % больных выздоравливают.
Общая выживаемость пациентов с нефробластомой в Республике Беларусь — 92 %, бессобытийная выживаемость — 90 %, что соответствует результатам лечения групп NWTS и SIOP.
Случай из практики
Девочка, 4 года. Мама обратила внимание на наличие дополнительного образования в животе. В связи с этим ребенок был госпитализирован в одну из областных клиник, проведено обследование, обнаружена опухоль брюшной полости. Ребенок переведен в РНПЦ ДОГИ для дообследования.
![KT 2]()
Рисунок 2. КТ: опухоль при поступлении. Клинически: при пальпации опухоль в проекции правой почки до 12 см в диаметре. Общеклинические исследования в пределах возрастной нормы. При КТ органов брюшной и грудной полости: КТ-картина объемного образования правой почки без признаков интрапульмональных метастазов (см. рис. 2). УЗИ брюшной полости: в проекции правой почки солидно-кистозное образование 101ґ114ґ99 мм, объемом 500 мл, васкуляризация активная, интактная часть почки 57ґ12ґ40 мм. Объемное образование правой почки — опухоль Вильмса. Предварительный диагноз: опухоль Вильмса правой почки, 2-я стадия.
![KT 3]()
Рисунок 3. Контрольная КТ: опухоль после предоперационной химиотерапии. Ребенку проведена предоперационная химиотерапия. На 5-й неделе лечения КТ-контроль показал уменьшение опухоли в размерах до 90ґ80ґ100 мм (см. рис. 3).
Выполнена операция: лапаротомия, удаление опухоли правой почки с ее резекцией. Гистологическое заключение: классическая нефробластома, промежуточная группа риска (см. рис. 4).
Послеоперационная программа включала еженедельное введение трех препаратов: винкристин, дактиномицин, доксорубицин на протяжении 27 недель. Девочка перенесла лечение удовлетворительно, без осложнений, находится в ремиссии более 5 лет.
![Rezicirov pochka]()
Рисунок 4. Интраоперационная фотография: резецированная почка (справа), опухолевый узел (слева).
Читайте также: